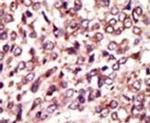
MGAT1 Antibody in Immunohistochemistry (IHC)

Search
Invitrogen
MGAT1 Polyclonal Antibody
{{$productOrderCtrl.translations['antibody.pdp.commerceCard.promotion.promotions']}}
{{$productOrderCtrl.translations['antibody.pdp.commerceCard.promotion.viewpromo']}}
{{$productOrderCtrl.translations['antibody.pdp.commerceCard.promotion.promocode']}}: {{promo.promoCode}} {{promo.promoTitle}} {{promo.promoDescription}}. {{$productOrderCtrl.translations['antibody.pdp.commerceCard.promotion.learnmore']}}
产品信息
PA5-12148
宿主/亚型
分类
类型
抗原
偶联物
形式
浓度
保存条件
运输条件
RRID
靶标信息
There are believed to be over 100 different glycosyltransferases involved in the synthesis of protein-bound and lipid-bound oligosaccharides. UDP-N-acetylglucosamine:alpha-3-D-mannoside beta-1, 2-N-acetylglucosaminyltransferase I is a medial-Golgi enzyme essential for the synthesis of hybrid and complex N-glycans. The protein, encoded by a single exon, shows typical features of a type II transmembrane protein. The protein is believed to be essential for normal embryogenesis. Several variants encoding the same protein have been found for this gene.
仅用于科研。不用于诊断过程。未经明确授权不得转售。